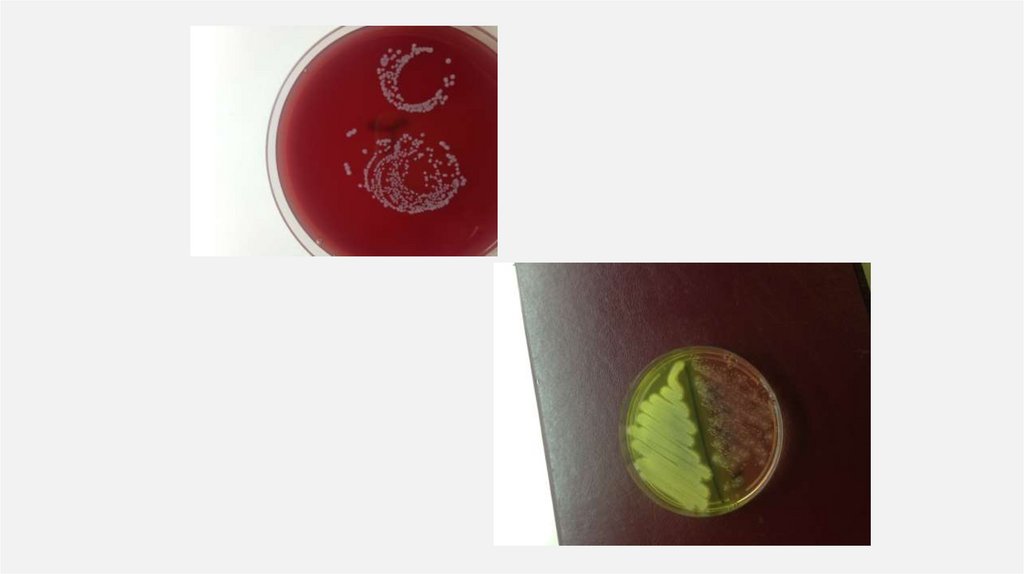

Similar presentations:
профилактика
1. Профилактика гемоконтактных инфекций
ПРОФИЛАКТИКАГЕМОКОНТАКТНЫХ ИНФЕКЦИЙ
Кафедра коммунальной гигиены СЗГМУ им. И.И. Мечникова
2. История вопроса
ИСТОРИЯ ВОПРОСА«Анатомический театр является единственным местом, где студенты могут
проводить время в ожидании вызова в акушерскую клинику…
Они занимаются на трупах и с препаратами.. А когда их вызывают в клинику на
противоположной стороне улицы, они отправляются туда, не проделав
никакой дезинфекции, часто даже просто не вымыв рук…
При таком положении роженицы могут с тем же успехом рожать прямо в
морге. Студенты и акушеры переходят улицу, вытирая руки, еще влажные
от трупной крови, носовыми платками, и прямо идут обследовать
рожениц.
В сущности говоря, акушерская клиника представляет собой не что иное, как
учреждение для массовых убийств…»
из письма ученика Земмельвейса, написанного в конце 50-х годов 19 в
3.
• До эксперимента (когда была введена практика обработки рук) уровеньсмертности среди рожениц в Венской больницы составлял 18%.
• После того как Земмельвейс предложил использовать раствор хлорной
извести для обработки рук и инструментов, уровень смертности снизился
примерно до 1%.
• Несмотря на успех, идею Земмельвейса медики восприняли “в штыки”. В
результате врач потерял работу, и, как полагают историки, у него случился
нервный срыв. Земмельвейс умер в психиатрической лечебнице возрасте 47
лет.
• «Врачи Вены были обижены предположением, что они могут распространять
инфекции. В то время большинство медиков были выходцами из среднего
или высшего класса, они считали себя очень чистоплотными людьми, по
сравнению с бедняками и людьми из низших слоев, — делится мнением
Нэнси Томес, профессор истории в Университете штата Нью-Йорк в СтоуниБрук. — Эти врачи считали, что Земмельвейс оскорбляет их честь, когда
говорит, что руки медиков могут быть грязными»
4.
• В конце XIX века английский хирург Джозеф Листер первым предложил своимколлегам мыть руки перед операцией, таким образом Листер открыл новую
антисептическую эру.
• Свой вклад в гигиену внесла и британская медсестра Флоренс Найтингейл,
которая внедрила в медицину стандарты ухода за больными, ставшие
революционными для того времени. В годы Крымской войны (1853—1856)
благодаря разработанным ей методам санитарии смертность в лазаретах
упала с 42% до 2%.
5. эпидпроцесс
ЭПИДПРОЦЕСС• Оспа
• Вызывала лихорадку, сыпь на коже и слизистых оболочках, частичную или
полную потерю зрения и многочисленные рубцы на месте бывших язв.
Летальность в зависимости от штамма составляла от 1% до 90%.
• Существовала болезнь несколько тысячелетий. В средневековье только в Европе
от нее умирало по полтора миллиона человек в год. Благодаря вакцинации эту
болезнь удалось полностью истребить. 14 мая 1796 года Эдвард Дженнер успешно
привил вирус коровьей оспы. В дальнейшем ему удалось доказать, что
вакцинация может победить болезнь. Так началась история уничтожения
болезни. После массовой вакцинации по плану, предложенному в 1958 году
советскими медиками, болезнь отступила. С оспой боролся весь мир – в
некоторых странах даже выплачивали вознаграждение тому, кто приведет
больного к врачам. Последний случай заражения в естественной среде
зарегистрировали в 1977 году. Сейчас вирусы оспы существуют только в двух
лабораториях – в центре «Вектор» (Россия) и в CDC (США).
6. Актуальность
АКТУАЛЬНОСТЬ• П. 3405 … Руки персонала играют наибольшее эпидемиологическое
значение в передаче инфекции (50%)
• П. 3480 Гигиеническую обработку рук осуществляют медицинские
работники на всех этапах оказания медицинской помощи, работники
пищеблоков, других подразделений, связанных с оказанием
медицинской помощи, а также осуществляющих уборку помещений,
обслуживание оборудования, другие работы в помещениях,
предназначенных для оказания медицинской помощи, пациенты и
члены их семей, другие лица при посещении пациентов и уходе за ними.
7.
8. Теоретическая подготовка медицинского персонала необходима для создания мотивации безусловного соблюдения гигиены рук и
Т Е О Р Е Т И Ч Е С К А Я П О Д Г О Т О В К А М Е Д И Ц И Н С КО Г О П Е Р С О Н А Л АН Е О Б ХОД И МА Д Л Я С О ЗД А Н И Я М ОТ И В А Ц И И Б Е З УС Л О В Н О ГО
С О Б Л Ю Д Е Н И Я Г И Г И Е Н Ы Р У К И И С П О Л Ь З О В А Н И Я П Е Р Ч АТ О К .
ОНА ВКЛЮЧАЕТ СЛЕДУЮЩИЕ ВОПРОСЫ
Виды манипуляций при работе с пациентом, которые могут контаминировать руки/перчатки.
Руки как основной фактор распространения клинически и эпидемически значимых штаммов
микроорганизмов, в том числе с множественной лекарственной устойчивостью.
• Показания к мытью рук мылом и водой, а также к обработке кожи рук спиртосодержащим
антисептиком.
• Сравнение эффективности методов. Особенности влияния мыла и спиртосодержащего
антисептика на кожу рук при многократном применении.
• Показания к использованию перчаток. Свойства перчаток, в том числе степень их
проницаемости для микроорганизмов и химических веществ.
• Виды перчаток, критерии выбора. Порядок надевания и снятия.
• Значение соблюдения гигиены рук в предупреждении циркуляции микроорганизмов с
множественной лекарственной устойчивостью к антимикробным препаратам, снижении
распространенности ИСМП и защите собственного здоровья.
9. Основные характеристики микрофлоры рук
ОСНОВНЫЕ ХАРАКТЕРИСТИКИМИКРОФЛОРЫ РУК
Резидентная микрофлора рук
Транзиторная микрофлора рук
постоянная
временная
количество снижается при гигиене рук
при гигиене рук в основном удаляется
размножается на/в коже
не размножается на/в коже
нормальная микрофлора кожи
возбудители ИСМП
нормальная микрофлора кожи рук и
их естественная
защита
патогенная микрофлора,
потенциальная опасность развития
ИСМП
Представители Enterobacteriaceae (Klebsiella spp., Enterobacter spp.) и
неферментирующие грамотрицательные
бактерии Acinetobacter spp. и др. могут стать резидентными при нарушении
микробиоценоза кожи
10. Сравнительная характеристика технологий гигиенической обработки рук
СРА В НИТ Е ЛЬНА Я Х А РА К Т Е Р ИСТ ИК А Т Е Х НОЛ О ГИЙГИГИЕНИЧЕСКОЙ ОБРАБОТ КИ РУ К
Характеристика
Обработка спиртосодержащим
антисептиком
Мытье мылом и водой
Условия применения
Наличие дозатора.
Легко применять у постели больного, при
входе в палату и т. д.
Наличие раковины для мытья рук, крана
с водой, дозатора для жидкого мыла,
полотенец однократного применения
При разбрызгивании воды возможна
контаминация одежды
Снижение количества транзиторных
микроорганизмов
В среднем в 10 000 раз
В среднем в 100...1000 раз
Механизм воздействия
Вызывает гибель микроорганизмов
Преимущественно механическое удаление, смывание
Антимикробный спектр
Быстрое воздействие и широкий
антимикробный спектр. Вместе
с тем не действует на споры бактерии Clostridium difficile.
Снижение количества микроорганизмов
достигается только смыванием. Предпочтительно при работе с больными
гастроэнтеритом
Время воздействия
20-30 секунд
не менее 1 минуты
Повреждение кожи рук
Менее выражено по сравнению
с мылом и водой. Добавление
смягчающих ингредиентов в препарат
способствует сохранению
гидролипидного слоя кожи рук.
При частом использовании происходит
повреждение липидов рогового слоя
кожи и ее высушивание, что является
причиной нарушения микробиоценоза
и потери защитных свойств кожи.
11. Правила обработки рук медицинского персонала
ПРАВИЛА ОБРАБОТКИ РУКМЕДИЦИНСКОГО ПЕРСОНАЛА
• Для достижения эффективного мытья и обеззараживания рук
необходимо соблюдать следующие условия:
• коротко подстриженные ногти,
• отсутствие лака на ногтях,
• отсутствие искусственных ногтей,
• отсутствие на руках колец, перстней и других ювелирных украшений.
• Перед обработкой рук необходимо снять часы, браслеты и другие.
12. Гигиеническую обработку рук кожным антисептиком проводят
ГИГИЕНИЧЕСКУЮ ОБРАБОТКУ РУККОЖНЫМ АНТИСЕПТИКОМ ПРОВОДЯТ
• до и после непосредственного контакта с пациентом;
• после контакта с секретами или экскретами организма, слизистыми
оболочками, повязками; перед выполнением инвазивных процедур (до
контакта с инвазивным оборудованием);
• после контакта с медицинским оборудованием и другими объектами,
находящимися в непосредственной близости от пациента;
• при переходе от более контаминированного микроорганизмами участка тела
пациента к менее контаминированному при оказании медицинской помощи
пациенту;
• перед надеванием медицинских перчаток и после их снятия.
13.
14. Основными мерами, направленными на снижение риска развития контактного дерматита у медицинских работников при высокой частоте
О С Н О В Н Ы М И М Е РА М И , Н А П РА В Л Е Н Н Ы М И Н А С Н И Ж Е Н И Е Р И С К АРА З В И Т И Я КО Н ТА К Т Н О Г О Д Е Р М АТ И ТА У М Е Д И Ц И Н С К И Х РА Б О Т Н И КО В
П Р И В Ы С О КО Й Ч А С Т О Т Е В Ы П О Л Н Е Н И Я Г И Г И Е Н И Ч Е С КО Й О Б РА Б О Т К И ,
ЯВЛЯЮТСЯ:
• минимизация контакта с водой и растворами без применения
защитных перчаток;
• снижение частоты мытья мылом и водой в пользу обработки рук
антисептиком;
• регулярное использование защитных кремов и увлажняющих
средств ухода за кожей рук, в том числе в течение
рабочей смены, для чего следует убедиться в их совместимости с
применяемыми антисептиками;
• обучение правилам защиты кожи рук и алгоритмам безопасной
работы.
15. Использование перчаток. Показания:
ИСПОЛЬЗОВАНИЕ ПЕРЧАТОК.ПОКАЗАНИЯ:
• во всех случаях, когда возможен контакт с кровью или другими
биологическими субстратами, в том числе во время уборки помещений;
• при контакте со слизистыми оболочками, с раневой поверхностью;
• при контакте с поврежденной кожей;
• при контакте с инфицированными пациентами;
• при контакте с агрессивными жидкостями;
• при использовании колющих и режущих инструментов;
• при проведении инвазивных диагностических и лечебных манипуляций;
• при работе с медицинскими отходами.
16. Медицинские перчатки и их защитные свойства
МЕДИЦИНСКИЕ ПЕРЧАТКИ И ИХЗАЩИТНЫЕ СВОЙСТВА
Фактор
воздействия
Материал
латексные
виниловые
нитриловые
неопреновые
Микроорганизмы
+
+
+
+
Лекарственные
средства
+
-
+
+
Цитостатики
+
-
+
0
Дез. Средства
-
+
+
+
Масла
-
+
-
-
Растворители
0
0
+
-
17. Важные аспекты
ВАЖНЫЕ АСПЕКТЫ• 3487. Перчатки надевают после полного высыхания антисептика на коже
рук. При наличии на руках микротравм, царапин, ссадин место
повреждения заклеивается лейкопластырем.
• 3490. После снятия перчаток следует провести гигиеническую обработку
рук кожным антисептиком. Новую пару перчаток надевать на высохшие
руки.
• 3491. Использованные перчатки после парентеральных манипуляций, в
том числе перевязок, удаляют как медицинские отходы класса Б.
18. Техника снятия перчаток
ТЕХНИКА СНЯТИЯ ПЕРЧАТОК19. Хирургическая обработка рук. Показания:
ХИРУРГИЧЕСКАЯ ОБРАБОТКА РУК.ПОКАЗАНИЯ:
• выполнение любых оперативных вмешательств или других процедур,
манипуляций любой продолжительности, сложности, локализации;
• катетеризация магистральных сосудов;
• установка инвазивного/дренажного устройства;
• пункция тканей, полостей, сосудов, спинномозговых каналов;
• выполнение стерильных эндоскопических манипуляций;
• прием родов.
20.
21. Техника нанесения ухаживающих средств
ТЕХНИКА НАНЕСЕНИЯ УХАЖИВАЮЩИХСРЕДСТВ
22. Техника нанесения ухаживающих средств
ТЕХНИКА НАНЕСЕНИЯ УХАЖИВАЮЩИХСРЕДСТВ
• 1. Нанести крем на тыльные поверхности рук.
• 2. Втереть крем в кожу тыльной поверхности
рук.
• 3. Втереть крем в кожу околоногтевой области
и в подушечки пальцев.
• 4. Втереть крем в кожу между пальцами
23. Основные документы, регламентирующие требования
ОСНОВНЫЕ ДОКУМЕНТЫ,РЕГЛАМЕНТИРУЮЩИЕ ТРЕБОВАНИЯ
• СанПиН
3.3686-21
«Санитарно-эпидемиологические
профилактике инфекционных болезней», раздел XLIV
требования
по
• Методические указания МУ 3.5.1.3674-20 «Обеззараживание рук медицинских
работников и кожных покровов пациентов при оказании медицинской помощи»
• Методические рекомендации MP 3.5.1.0113-16 «Использование перчаток для
профилактики инфекций, связанных с оказанием медицинской помощи, в
медицинских организациях»
• Требования к организации и проведению внутреннего контроля качества и
безопасности медицинской деятельности;
• Приказ Министерства здравоохранения Российской Федерации от 28 января
2021 г. N 29н «Об утверждении порядка проведения обязательных
предварительных и периодических медицинских осмотров работников,
предусмотренных частью четвертой статьи 213 трудового кодекса Российской
Федерации, перечня медицинских противопоказаний к осуществлению работ с
вредными и (или) опасными производственными факторами, а также работами,
при выполнении которых проводятся обязательные предварительные и
периодические медицинские осмотры».
24. Национальный календарь профилактических прививок
НАЦИОНАЛЬНЫЙ КАЛЕНДАРЬПРОФИЛАКТИЧЕСКИХ ПРИВИВОК
Категории и возраст граждан, подлежащих обязательной
вакцинации
Наименование профилактической прививки
Взрослые от 18 лет
Ревакцинация против дифтерии, столбняка - каждые 10 лет от момента
последней ревакцинации
Женщины от 18 до 25 лет (включительно), не болевшие, не привитые,
привитые однократно против краснухи, не имеющие сведений о
прививках против краснухи
Вакцинация против краснухи, ревакцинация против краснухи
Взрослые от 18 до 35 лет (включительно), не болевшие, не привитые,
привитые однократно, не имеющие сведений о прививках против кори;
взрослые от 36 до 55 лет (включительно), относящиеся к группам
риска (работники медицинских организаций), не болевшие, не
привитые, привитые однократно, не имеющие сведений о прививках
против кори
Вакцинация против кори, ревакцинация против кори
Взрослые от 18 до 55 лет, не привитые ранее против вирусного
гепатита В
Вакцинация против вирусного гепатита B
Работающие по отдельным профессиям и должностям (работники
медицинских организаций)
Вакцинация против гриппа
25. Календарь профилактических прививок по эпидемическим показаниям
КА ЛЕНДАРЬ ПРОФИЛАК ТИЧЕСКИХ ПРИВИВОКПО ЭПИДЕМИЧЕСКИМ ПОКАЗАНИЯМ
Категории и возраст граждан, подлежащих обязательной
вакцинации
Наименование профилактической прививки
Против коронавирусной инфекции,
вызываемой вирусом SARS-CoV-2
К приоритету 1-го уровня относятся:
лица в возрасте 60 лет и старше;
взрослые, работающие по отдельным профессиям и должностям:
работники медицинских организаций, граждане, проживающие в городах с
численностью населения 1 млн и более.
26. Обследование на наличие HBsAg в сыворотке (плазме) крови
ОБСЛЕДОВАНИЕ НА НАЛИЧИЕ HBSAG ВСЫВОРОТКЕ (ПЛАЗМЕ) КРОВИ
• Приложение 16 к СанПиН 3.3686-21
Контингенты населения
Период обследования
Персонал медицинских организаций:
- центров, отделений гемодиализа, трансплантации органов,
гематологии;
При приеме на работу и далее 1 раз в год, дополнительно - по
показаниям
Пациенты центров и отделений гемодиализа, пересадки почки,
сердечно-сосудистой и легочной хирургии, гематологии
При поступлении;
при необходимости по клиническим и эпидемиологическим
показаниям
27. Обследование на наличие ANTI-HCV в сыворотке (плазме) крови
ОБСЛЕДОВАНИЕ НА НАЛИЧИЕ A NTI-HCVВ СЫВОРОТКЕ (ПЛАЗМЕ) КРОВИ
• Приложение 17 к СанПиН 3.3686-21
Контингенты населения
Период обследования
Персонал медицинских организаций:
- центров, отделений гемодиализа, трансплантации органов,
гематологии;
При приеме на работу и далее 1 раз в год, дополнительно - по показаниям
Пациенты центров и отделений гемодиализа, пересадки почки,
сердечно-сосудистой и легочной хирургии, гематологии
При поступлении;
при необходимости по клиническим и эпидемиологическим показаниям
28. Обследование на наличие ВИЧ
ОБСЛЕДОВАНИЕ НА НАЛИЧИЕ ВИЧ• Приказ Министерства здравоохранения Российской Федерации от 28 января 2021 г. N 29н. П.2.3. –
Аллергены для диагностики и лечения(А), компоненты и препараты крови, иммунобиологические
препараты(А) – 1 раз в год.
29. Профилактика гемоконтактных инфекций при возникновении аварийных ситуаций
П РО Ф И Л А К Т И К А Г Е М О К О Н ТА К Т Н Ы Х И Н Ф Е К Ц И ЙП Р И ВО З Н И К Н О В Е Н И И А ВА Р И Й Н Ы Х С И Т УА Ц И Й
• Наличие укладок экстренной профилактики гемоконтактных
инфекций (Приложение №1 Приказа МЗ РФ от 09.01.2018 №1н);
• Наличие журнала «Учет аварийных ситуаций при проведении
медицинских манипуляций» (СанПиН 3.3686-21 "Санитарноэпидемиологические требования по профилактике инфекционных
болезней«);
• Акт «О медицинской аварии в учреждении» (Приложение 15 СанПиН
3.3686-21).
30. Состав укладки экстренной профилактики гемоконтактных инфекций
СОСТАВ УКЛА ДКИ ЭКСТРЕННОЙПРОФИЛАК ТИКИ ГЕМОКОНТАК ТНЫХ
ИНФЕКЦИЙ
Кол-во, не менее
Лекарственные препараты
Антисептики и дезинфицирующие средства
Йод (раствор для наружного применения 5%)
1 шт.
Этанол (раствор для наружного применения 70%)
1 шт.
Медицинские изделия
Бинт марлевый медицинский стерильный (5м*10см)
2 шт.
Лейкопластырь бактерицидный (не менее 1,9 см*7,2 см)
3 шт.
Салфетка марлевая медицинская стерильная (не менее 16
см*14 см, №10)
1 уп.
31. Профилактика гемоконтактных инфекций при возникновении аварийных ситуаций
П РО Ф И Л А К Т И К А Г Е М О К О Н ТА К Т Н Ы Х И Н Ф Е К Ц И ЙП Р И ВО З Н И К Н О В Е Н И И А ВА Р И Й Н Ы Х С И Т УА Ц И Й
1. Оказать первую помощь, воспользовавшись укладкой профилактики парентеральных инфекций;
2. Сделать запись в журнале «Учет аварийных ситуаций при проведении медицинских манипуляций»;
3. Сообщить руководству.
Медицинский сотрудник,
получивший травму
4. Составить акт «О медицинской аварии в учреждении»;
5. Обследование на гемоконтактные инфекции методом экспресс – тестирования.
6. Отправить сотрудника, с заполненным актом в центр СПИД, либо к уполномоченному инфекционисту
кабинета инфекционных заболеваний поликлиники по месту жительства.
Руководитель
подразделения
7. Начать приём антиретровирусных препаратов в течении первых 2х часов, но не позднее 72 часов.
Срок диспансерного наблюдения пациентов, пострадавших в аварийных ситуациях, составляет 1 год.
Периодичность обследования на антитела к ВИЧ: В день аварийной ситуации, через 3, 6, 12 месяцев.
Медицинский сотрудник,
получивший травму
32. Алгоритм обработки места контакта с биологической жидкостью
АЛГОРИТМ ОБРАБОТКИ МЕСТАКОНТАК ТА С БИОЛОГИЧЕСКОЙ
ЖИДКОСТЬЮ
• 1. При повреждении кожи (Порезе или проколе) инструментами, загрязненными кровью пациента
• Перчатки обработать салфеткой, смоченной дез.средством;
• Снять перчатки;
• Руки вымыть и дважды обработать 70% спиртом;
• Смазать рану 5% спиртовой настойкой йода;
• Заклеить поврежденное место лейкопластырем;
33. Алгоритм обработки места контакта с биологической жидкостью
АЛГОРИТМ ОБРАБОТКИ МЕСТАКОНТАК ТА С БИОЛОГИЧЕСКОЙ
ЖИДКОСТЬЮ
• 2. При загрязнении кожи рук выделениями, кровью необходимо:
• Вымыть руки мылом и водой;
• Тщательно высушить руки одноразовым полотенцем;
• Дважды обработать руки спиртсодержащим антисептиком или 70% спиртом.
• Руки в загрязненных перчатках:
• Обработать салфеткой смоченной дезинфицирующим средством;
• Снять перчатки, руки вымыть и дважды обработать спиртсодержащим
антисептиком или 70% спиртом.
34. Алгоритм обработки места контакта с биологической жидкостью
АЛГОРИТМ ОБРАБОТКИ МЕСТАКОНТАК ТА С БИОЛОГИЧЕСКОЙ
ЖИДКОСТЬЮ
• 3. При попадании крови на слизистую оболочку полости рта, глаз,
носа
• Промыть обильно под проточной водой (не тереть).
35. Алгоритм обработки места контакта с биологической жидкостью
АЛГОРИТМ ОБРАБОТКИ МЕСТАКОНТАК ТА С БИОЛОГИЧЕСКОЙ
ЖИДКОСТЬЮ
• 4. При попадании биологических жидкостей пациента на
рабочую одежду
• Рабочую одежду снять, соблюдая меры предосторожности;
• Поместить рабочую одежу в бак для проведения дезинфекции
или поместить в герметичный мешок для проведения
последующей дезинфекции и стирки;
• Принять душ;
• Надеть новую рабочую одежду.
36. Журнал «Учет аварийных ситуаций при проведении медицинских манипуляций»
Ж У Р Н А Л « У Ч Е Т А ВА Р И Й Н Ы Х С И Т УА Ц И Й П Р И П РО В Е Д Е Н И ИМ Е Д И Ц И Н С К И Х М А Н И П УЛ Я Ц И Й »
• Приложение 14 СанПиН 3.3686-21 "Санитарно-эпидемиологические требования по профилактике
инфекционных болезней"
№
Фамилия, имя, отчество
(последнее при наличии)
пострадавшего медицинского
работника
Место
работы,
должность
Возраст
Дата и
время
аварии
Обстоятельства
и характер
аварии
Наличие
СИЗ
Фамилия, имя, отчество
(последнее при наличии)
больного, адрес, №
истории болезни, дата и
результат обследования
на ВИЧ, ВГВ, ВГС,
стадия ВИЧ-инфекции
Объемы
оказываем
ой помощи
пострадав
шим
Фамилия, имя,
отчество (последнее при наличии)
руководителя,
которого
проинформировали
об аварии
37. Акт «О медицинской аварии в учреждении»
АКТ «О МЕДИЦИНСКОЙ АВАРИИ ВУЧРЕЖДЕНИИ»
• Акт составляется в 2х экземплярах, один остается
в медицинском учреждении,
• со вторым экземпляром пострадавший
направляется в центр СПИД.
38. Профилактика гемоконтактных инфекций
ПРОФИЛАКТИКА ГЕМОКОНТАКТНЫХИНФЕКЦИЙ
Использование средств индивидуальной защиты.
39. Периоды инфекционных болезней: Инкубационный период (скрытый)
ПЕРИОДЫ ИНФЕКЦИОННЫХ БОЛЕЗНЕЙ :ИНКУБАЦИОННЫЙ ПЕРИОД (СКРЫТЫЙ)
• Возникает с момента заражения и длится до появления первых
клинических признаков.
• При некоторых инфекциях он исчисляется часами (грипп), неделями
(гепатит А), месяцами (гепатит В), годами (лепра). Продолжительность
инкубационного периода зависит от реактивности организма человека,
дозы и вирулентности возбудителя. Большинство инфекционных
болезней имеют инкубационный период от 1 до 3 недель.
40. Периоды инфекционных болезней: Продромальный период (период предвестников)
ПЕРИОДЫ ИНФЕКЦИОННЫХ БОЛЕЗНЕЙ:ПРОДРОМАЛЬНЫЙ ПЕРИОД
(ПЕРИОД ПРЕДВЕСТНИКОВ)
• Для него характерны неспецифические признаки: недомогание, повышение
температуры, головная боль, расстройство сна, которые могут быть при
многих инфекционных болезнях. Поэтому диагностика в этот период
затруднена. Иногда в этом периоде могут проявляться характерные признаки
(при кори – на слизистых щек пятна Филатова-Коплика-Бельского),
помогающие ранней диагностике. Чаще всего длитя 1-3 дня. Многие
инфекционные заболевания могут протекать без периода предвестников.
• Вслед за этим происходит нарастание клинических симптомов и заболевание
переходит в период разгара клинических проявлений, для которого
характерен весь симптомокомплекс, включающий специфические признаки
41. Периоды инфекционных болезней: период разгара клинических проявлений
ПЕРИОДЫ ИНФЕКЦИОННЫХ БОЛЕЗНЕЙ:ПЕРИОД РАЗГАРА
КЛИНИЧЕСКИХ ПРОЯВЛЕНИЙ
• Вслед за продромой происходит нарастание клинических симптомов и
заболевание переходит в период разгара клинических проявлений, для
которого характерен весь симптомокомплекс, включающий
специфические признаки (например желтуха при вирусном гепатите,
сыпь при кори, скарлатине, сыпном тифе, брюшном тифе и т.д.).
42. Периоды инфекционных болезней: период угасания симптомов выздоровление (реконвалесценция)
ПЕРИОДЫ ИНФЕКЦИОННЫХ БОЛЕЗНЕЙ:ПЕРИОД УГАСАНИЯ СИМПТОМОВ
ВЫЗДОРОВЛЕНИЕ (РЕКОНВАЛЕСЦЕНЦИЯ)
• Происходит восстановление нарушенной внутренней среды организма,
при участии механизмов защиты. Длительность периода выздоровления
варьируется в зависимости от формы заболевания, тяжести течения,
защитных сил организма, эффективности лечения и пр.
• Исходом инфекционного заболевание могут быть переход в
хроническую форму, инвалидность, формирование
бактерионосительства. Возможен летальный исход.
43. Формы Течения заболевания
ФОРМЫ ТЕЧЕНИЯ ЗАБОЛЕВАНИЯ• По тяжести течения инфекционные заболевания подразделяются на
тяжелые, средней тяжести, легкие формы
• Тяжелая форма характеризуется резко выраженной симптоматикой,
продолжительным течением, нередко наличием осложнений. Для форм
средней тяжести типичны ярко выраженные клинические симптомы,
непродолжительное течение и обычно благоприятный исход. При
легком течении симптомы болезни выражены нерезко. Могут быть
молниеносные формы заболевания, которые протекают очень тяжело, с
быстрым развитием всех клинических симптомов, часто заканчиваются
летально. Различие по форме тяжести заболеваний требует разного
подхода к назначению и дозировке препаратов.
44. Формы Течения заболевания
ФОРМЫ ТЕЧЕНИЯ ЗАБОЛЕВАНИЯ• По продолжительности течения инфекционные заболевания делятся на острые,
подострые и хронические. Некоторым заболеваниям свойственно лишь острое течение
(холера, грипп, корь), другие склонны к хроническому течению (бруцеллез, вирусный
гепатит). В случае снижения защитных сил организма могут возникнуть осложнения,
например, миокардит при дифтерии, тромбоз сосудов при сыпном тифе. Нередко
наблюдается осложнение, связанное с активацией микробов, находящихся в организме
больного. К таким осложнениям относятся пневмония, отит, абсцессы. Инфекционные
болезни, вызванные одним видом микроорганизмов, получили название
моноинфекций, вызванных неколькими видами микробов – микстинфекций (смешанная
инфекция) От смешанной инфекции следует отличать вторичную инфекцию, когда к
уже развившейся инфекционной болезни присоединяется другая. Повторное
заболевание той же самой инфекционной болезнью называется реинфекцией
(малярия, дизентерия). Возврат симптомов заболевания в результате ослабления
защитных сил организма называется рецидивом (болезнь Брилля при сыпном тифе,
брюшной тиф).
45. причины
ПРИЧИНЫ• Причиной развития инфекционных болезней является внедрение в
организм человека патогенного возбудителя. Формы взаимодействия
инфекционного агента и организма разнообразны и зависят от свойств
возбудителя, особенностей реактивной среды организма человека и
условий окружающей среды.
46. ВИЧ-инфекция (спид)
ВИЧ-ИНФЕКЦИЯ (СПИД)• Это актуальная проблема не только для медработников, но и для общества в
целом. Первые случаи ВИЧ-инфекции зарегистрированы в США, заболевание
поражало наркоманов, гомосексуалистов и людей занимающихся
коммерческим сексом. Но, вскоре, ситуация изменилась, заболевать стали
дети, роженицы, пожилые люди, люди с гемофилией.
• В России первый случай был завозным, ВИЧ-инфекцию обнаружили у
работника Российского посольства в Танзании, как выяснилось,
гомосексуалиста. Первые крупные вспышки инфекции возникли в г. Элисте,
затем в Ростове-на-Дону, Волгограде среди детей, находящихся на
стационарном лечении в больницах этих городов, т.е. эти случаи –
результаты парентеральной передачи вируса. В настоящее время количество
инфицированных и больных людей резко возросло, эпидемия набирает силу.
47. ВИЧ-инфекция (спид)
ВИЧ-ИНФЕКЦИЯ (СПИД)• СПИД – синдром приобретенного иммунодефицита – наименование
инфекции неточное, так как:
• 1) приобретенный иммунодефицит может развиваться под действием
радиации, в результате применения цитостатических препаратов,
кортикостероидов, в связи с такими заболеваниями как туберкулез,
сахарный диабет, онкологические заболевания.
• 2) во-вторых, СПИД – это терминальная, последняя стадия болезни, до
которой, от момента заражения могут пройти месяцы, годы.
• Следовательно более правильное наименование - ВИЧ-инфекция.
48. ВИЧ-инфекция (спид) ЭТИология
ВИЧ-ИНФЕКЦИЯ (СПИД)ЭТИОЛОГИЯ
• В настоящее время известно три типа вируса: ВИЧ-1, ВИЧ-2, ВИЧ-3,
наиболее распространенный – ВИЧ-1.
• В организме возбудитель находится во всех жидких средах, но
наибольшая концентрация достигается в крови, выделениях влагалища,
семенной жидкости. Вирус неустойчив к физическим и химическим
воздействиям. Он инактивируется при нагревании до 56 градусов С в
течение 10 минут; под влиянием хлорсодержащих препаратов, спирта,
перекиси водорода погибает мгновенно. В желудочно-кишечном тракте
вирус разрушается пищеварительными ферментами, соляной кислотой.
Устойчивость проявляет к УФО и гамма-лучам.
49. ВИЧ-инфекция (спид) патогенез
ВИЧ-ИНФЕКЦИЯ (СПИД)ПАТОГЕНЕЗ
• ВИЧ поражает иммунные клетки – Т-лимфоциты (хелперы). В результате
эти клетки погибают. Одновременно появляются антитела, которые не
защищают от инфицирования, так как вирус находится внутри
лимфоцитов, пораженные лимфоциты погибают. Постепенное
уменьшение лимфоцитов приводит к угнетению иммунной системы,
человек становится восприимчивым к любой инфекции.
50. ВИЧ-инфекция (спид) Эпидемиология
ВИЧ-ИНФЕКЦИЯ (СПИД)ЭПИДЕМИОЛОГИЯ
• Источником инфекции являются больные люди и вирусоносители.
• Доказаны следующие пути передачи:
- Половой;
- Парентеральный;
- Трансплацентарный.
51. ВИЧ-инфекция (спид) Эпидемиология
ВИЧ-ИНФЕКЦИЯ (СПИД)ЭПИДЕМИОЛОГИЯ
• Ведущее место занимает половой путь передачи.
• Парентеральная передача инфекции возникает при повторном
использовании инфицированных игл и шприцев, как в быту у
наркоманов, так и в медицинских учреждениях, при нарушении правил
стерилизации инструментов. Заражение возможно при переливании
крови и ее препаратов, полученных от ВИЧ-инфицированного человека.
• Трансплацентарная передача заболевания от инфицированной матери
ребенку возникает в 50% случаев. Другая вероятность заражения
ребенка во время родов, когда происходит контакт со слизью и кровью
матери. Предполагается, что ребенок может заражаться от матери во
время кормления грудным молоком.
52. ВИЧ-инфекция (спид) Эпидемиология
ВИЧ-ИНФЕКЦИЯ (СПИД)ЭПИДЕМИОЛОГИЯ
Для эпидемиологического надзора определены группы риска – т.е. контингент лиц, подвергающихся
высокой степени риска заражения ВИЧ-инфекцией. К ним относятся:
-
Лица нетрадиционной сексуальной ориентации
-
Работники коммерческого секса
-
Наркоманы (инъекционные)
-
Половые партнеры лиц, инфицированных ВИЧ-инфекцией
-
Дети, родившиеся от ВИЧ-положительных матерей
-
Больные гемофилией
-
Больные венерическими заболеваниями
-
Больные вирусными гепатитами В, С
-
Медицинские работники, имеющие контакт с кровью и другим биологическим материалом больных.
53. ВИЧ-инфекция (спид) Эпидемиология
ВИЧ-ИНФЕКЦИЯ (СПИД)ЭПИДЕМИОЛОГИЯ
• Не установлено заражение через пищу, воду, бытовые предметы, при
пользовании общим туалетом в быту и по месту работы и учебы, через
кровососущих насекомых.
• Нельзя исключать возможности заражения при маникюре, педикюре,
бритье, татуировке.
54. ВИЧ-инфекция (спид) Клиника
ВИЧ-ИНФЕКЦИЯ (СПИД)КЛИНИКА
!-я стадия – инкубация, длится от 6 недель до 5-8 лет. Антитела к ВИЧ можно обнаружить не ранее минимального срока
инкубации, т.е. через 6 недель.
2-я стадия – стадия первичных проявлений, может протекать:
-
А – бессимптомно;
-
Б – по типу острой лихорадки;
-
В – как персистирующая генерализованная лимфаденопатия
3-я стадия – стадия вторичных заболеваний протекает в три фазы:
А – потеря массы тела менее 10% от общей массы, поверхностные бактериальные, вирусные и грибковые поражения
кожи;
Б – прогрессирующая потеря массы тела более 10% от массы тела, необъяснимая диарея или лихорадка более 1 месяца ;
глубокие поражения кожных покровов и слизистых различными микроорганизмами.
В – генерализованные поражения (бактериальные, вирусные, грибковые, протозойные и т.д.); вызывать заболевания
могут патогенные, условно-патогенные и непатогенные микроорганизмы. Например, у больных СПИДом может
развиваться пневмония, вызванная непатогенной пневмоцистой. Заболевания протекают по септическому варианту,
одно инфекционное заболевание сменяется другим, возможно сочетание нескольких инфекций. В этой же фазе могут
развиваться злокачественные опухоли, так называемая саркома Капоши. Поражается центральная нервная система, что
выражается в прогрессирующем слабоумии. При определении иммунного статуса отмечается иммунодефицит, т.е.
развивается СПИД и заболевание переходит в терминальную стадию.
55. ВИЧ-инфекция (спид) лечение
ВИЧ-ИНФЕКЦИЯ (СПИД)ЛЕЧЕНИЕ
• Так как инкубационный период может быть продолжительным (до 10-15 лет), нужно
соблюдать особую осторожность.
• При положительном тесте на ВИЧ-инфекцию медработник должен сообщить об этом
пациенту. У пациента возникают самые различные реакции на такое известие: страх смерти,
отчаяние, опасение, что об этом узнаю родные, близкие, друзья, коллеги, соседи и так далее.
Поэтому можно обозначить следующие проблемы у такого человека:
- Стрессовое состояние;
- Страх потерять любимого человека, семью;
- Страх потерять друзей;
- Страх потерять работу;
- Невозможность получить образование;
- Невозможность получить медицинскую помощь;
- Страх смерти.
56. ВИЧ-инфекция (спид) лечение
ВИЧ-ИНФЕКЦИЯ (СПИД)ЛЕЧЕНИЕ
На данном этапе инфекции у пациента независимые вмешательства медсестры направлены на оказание
психосоциальной помощи:
-
Необходимо проинформировать пациента о том, что инкубационный период может длиться очень долго, наука
продолжает создавать новые, все более эффективные лекарственные препараты, значительно продлевающие
жизнь. Пациент должен и может вести продуктивный образ жизни, отказаться от вредных привычек (курение,
алкоголь), заниматься спортом, закаливанием, что повышает его иммунитет;
-
Необходимо побудить пациента к тому, чтобы он сообщил своим родным о своем состоянии, при этом медсестра
должна быть помощником пациента, консультантом для его родных, знакомых;
-
Пациент должен быть проинформирован, в каких случаях он может быть опасен как источник инфекции (половой
путь передачи, парентеральный, трансплацентарный), какие формы секса не представляют угрозу заражения
партнера. В противном случае ВИЧ-инфицированный несет уголовную ответственность за создание угрозы
заражения;
-
Медсестра обязана сохранять медицинскую тайну о заболевании пациента (без служебной необходимости), что
поможет пациенту сохранить место работы, круг знакомых;
-
Медсестра должна постоянно разъяснять людям основы безопасного общения с ВИЧ-положительным в быту, что
также уменьшает напряжение в коллективах и семьях;
-
Необходимо объяснить пациенту и членам семьи, что ВИЧ-инфекция передается плоду или во время родов в 50%
случаев, если супруги все-таки решают иметь ребенка, им необходимо пройти лечение, что снижает риск
инфицирования потомства до 8-2%;
-
Пациент имеет право на оказание ему медицинской помощи в любом медицинском учреждении.
57. ВИЧ-инфекция (спид) лечение
ВИЧ-ИНФЕКЦИЯ (СПИД)ЛЕЧЕНИЕ
• Цель ухода за больными СПИДом:
- Облегчение клинических симптомов;
- Максимальное повышение уровня функций организма и качества жизни;
- Обеспечение инфекционной безопасности в окружении больного, а
также для самого пациента.
58. ВИЧ-инфекция (спид) лечение
ВИЧ-ИНФЕКЦИЯ (СПИД)ЛЕЧЕНИЕ
• Зависимые вмешательства медсестры:
- Обеспечение правильного и регулярного приема лекарственных
препаратов;
- Помощь врачу при выполнении сложных медицинских вмешательств
(пункция, интубация и другое);
- Взятие крови и другого биологического материала у пациента для
лабораторной диагностики.
59. ВИЧ-инфекция (спид) лечение
ВИЧ-ИНФЕКЦИЯ (СПИД)ЛЕЧЕНИЕ
• Медсестра должна работать в перчатках, маске.
• Лечение зависит от стадии заболевания, от уровня СД-4 лимфоцитов, от
уровня РНК, ВИЧ и других показателей.
60. ВИЧ-инфекция (спид) Химиопрофилактика
ВИЧ-ИНФЕКЦИЯ (СПИД)ХИМИОПРОФИЛАКТИКА
• Химиопрофилактика парентерального и полового заражения. Методы
профилактики парентерального заражения ВИЧ проводятся
медработникам, получившим травмы инструментом,
контаминированным ВИЧ.
• Химиопрофилактику желательно начинать как можно раньше (в первые
минуты). Сочетать с местной обработкой, используя аптечку
процедурного кабинета.
• Применение противовирусных препаратов с целью возможного
снижения риска полового заражения ВИЧ рекомендуется в случаях
«аварии» при применении презерватива (разрыв и т.д.).
61. ВИЧ-инфекция (спид) профилактика
ВИЧ-ИНФЕКЦИЯ (СПИД)ПРОФИЛАКТИКА
• Предупреждение передачи инфекции в медицинских учреждениях.
• Передача ВИЧ-инфекции в медицинских учреждениях может произойти:
от больного к больному, от больного к медработнику, от медработника к
больному. Передача от больного к больному может произойти
косвенным путем через зараженную кровь, оставшуюся на иглах,
шприцах, другом инструменте, если они не были обработаны и
простерилизованы должным образом перед повторным использованием.
62. ВИЧ-инфекция (спид) профилактика
ВИЧ-ИНФЕКЦИЯ (СПИД)ПРОФИЛАКТИКА
• Передача от больного к медицинскому работнику может произойти,
когда медработник имеет контакт с кровью ВИЧ-инфицированного
(например, при уколах, порезах, при попадании крови на слизистую
оболочку глаза, носа, рта – при разбрызгивании крови).
63. ВИЧ-инфекция (спид) профилактика
ВИЧ-ИНФЕКЦИЯ (СПИД)ПРОФИЛАКТИКА
• Передача от медицинского работника больному возможна, но вероятность мала. Медработник должен
неукоснительно применять все существующие меры предосторожности:
• 1) Профилактика уколов, порезов, царапин.
• 2) После контакта с жидкостями организма необходимо тщательно мыть руки с мылом, сухую, шершавую
кожу обрабатывать кремом.
• 3) Разлившиеся жидкости обеззараживать хлорсодержащими дезинфицирующими средствами, можно водой
с мылом.
• 4) Барьерные меры предосторожности: использование перчаток, масок и защитных очков, дополнительных
халатов и передников из пластика.
• 5) Следует избегать излишних манипуляций с иглами после использования (не ломать, не сгибать).
• 6) Колющие и режущие предметы не следует передавать из рук в руки.
• 7) Одноразовые колющие и режущие предметы после использования сбрасывать в прочные контейнеры из
пластика или металла.
• 8) Разборку, мойку и прополаскивание медицинского инструментария, пипеток, лабораторной посуды,
приборов и аппаратов, соприкасающихся с кровью или сывороткой людей, проводить после
предварительной дезинфекции и в резиновых перчатках.
64. ВИЧ-инфекция (спид) профилактика
ВИЧ-ИНФЕКЦИЯ (СПИД)ПРОФИЛАКТИКА
• При проведении искусственного дыхания «изо рта в рот» передача ВИЧ не
установлена, но оказывающий помощь должен пользоваться чистой
салфеткой или носовым платком, чтобы осушить кровь, текущую изо рта.
• При кровотечении, если пострадавший может сам наложить повязку на рану,
медработник только консультирует, как это сделать. Если это невозможно, то
оказывающий помощь должен пользоваться перчатками, если они имеются,
если их нет, необходимо использовать материю или одежду для
предотвращения контакта.
• Очень важной частью профилактики ВИЧ-инфекции является
распространение информации о том, как предупредить передачу данного
заболевания. Многие люди продолжают сексуальную активность даже после
того, как узгают об опасности СПИДа. Поэтому важно научить людей
безопасным способам сексуальных отношений.
65.
ГепатитГепати́т —
воспалительные заболевания печени различной,
в том числе и вирусной этиологии. В общем
смысле характеризует любое воспаление
печени.
66.
Гепатит67.
Заболеваемость68.
Заболеваемость69.
Заболеваемость70.
Заболеваемость71.
Профилактика1.
Вакцинация
2.
Профилактика распространения через инвазивные манипуляции
(Дезинфекция и стерилизация ИМН!!!)
3.
Защищенный половой контакт
4.
Сознательный подход к косметическим процедурам
72.
ВакцинацияВакцинация населения против ГВ, являющаяся ведущим профилактическим мероприятием!!!
73. Гепатит В
ГЕПАТИТ В• Это опасная инфекция, вызываемая вирусом гепатита В, которая
поражает печень
• Хроническая или длительная инфекция приводит к тяжелому
повреждению печени, циррозу (рубцеванию печени) и
гепатоцеллюлярной карциноме (рак печени)
• Полностью излечиться от гепатита В невозможно, но лечение,
назначенное врачом, может замедлить повреждение печени.
74. Гепатит В
ГЕПАТИТ В• Гепатит В является глобальной проблемой здравоохранения
• 350-400 млн человек в мире инфицированы вирусом хронического
гепатита В, несмотря на доступность вакцины
• Гепатит В имеет высокую степень инфицирования, в 100 раз
превышающую степень инфицирования вируса иммунодефицита
человека (ВИЧ)
• Гепатит В стоит на десятом месте среди наиболее распространенных
причин смерти по всему миру
75. Гепатит В
ГЕПАТИТ В• Передается при:
- Прямом контакте крови инфицированного человека с кровью
незараженного человека
- Незащищенном сексуальном контакте
- Использовании нестерильных игл
- От инфицированной матери к ребенку при родах
76. Гепатит В
ГЕПАТИТ В• Другие пути заражения:
- Совместное использование с инфицированным человеком таких
предметов, как бритва, зубная щетка, серьги, пирсинг, а также при
нанесении татуировок и иглоукалывании нестерильными иглами
- Гепатит не передается случайно, то есть при чихании, кашле или приеме
пищи, приготовленной человеком, инфицированным вирусом.
77. Гепатит В
ГЕПАТИТ В- В зоне риска:
- Члены семьи
- Люди с несколькими половыми партнерами
- Дети, рожденные от инфицированных матерей
- Усыновленные дети из стран с высокой распространенностью гепатита В
- Медицинские работники
- Наркоманы инъекционные
- Люди с пирсингом/ татуировками
78. Гепатит В
ГЕПАТИТ В- Распространены симптомы:
- Лихорадка, утомление, боли в мышцах или суставах
- Потеря аппетита
- Умеренная тошнота и рвота
- Менее распространенные, но серьезные симптомы, при которых требуется
немедленная медицинская помощь:
- Сильная тошнита и рвота
- Желтуха (но бывает ложная)
- Вздутие живота
79. Гепатит В
ГЕПАТИТ В- Вирус ВГВ способен выживать более недели в засохшей крови
- Вакцинация наиболее эффективный способ профилактики
- Доступна с 1982 года
- Более 1 миллиарда человек прошли вакцинацию по всему миру.
80. Гепатит В
ГЕПАТИТ В- В вакцинации нуждаются:
- Медицинские работники;
- Люди, употребляющие инъекционные наркотики;
- Люди, часто меняющие половых партнеров;
- Дети от матерей с ХГВ
- Половые контакты с ХГВ
- Люди, посещающие медицинские учреждения или центры по изучению
инвалидности
- Пациенты, аппарат искусственная почка
81. Гепатит В
ГЕПАТИТ В- Иммунизация – наиболее эффективный способ профилактики инфекции
и ее последствий.
- Иммуноглобулин (ИГГВ) – немедленная иммунизация, которая защищает
от ВГВ, если была введена в течение 48 часов после возможного
инфицирования. Тем не менее, это дорогостоящая процедура и ее
действие длится около 3-6 месяцев.
82. Гепатит с
ГЕПАТИТ С- Антропоноз
- В среднем инкубация 8-9 недель
- Начинается с интоксикации, увеличения печени и селезенки,
симптоматики расстройства ЖКТ, желтухи.
- У 20-30% переболевших отмечается вирусоносильство
- Лечение неспецифическое (препараты А-интерферона)

medicine
medicine








